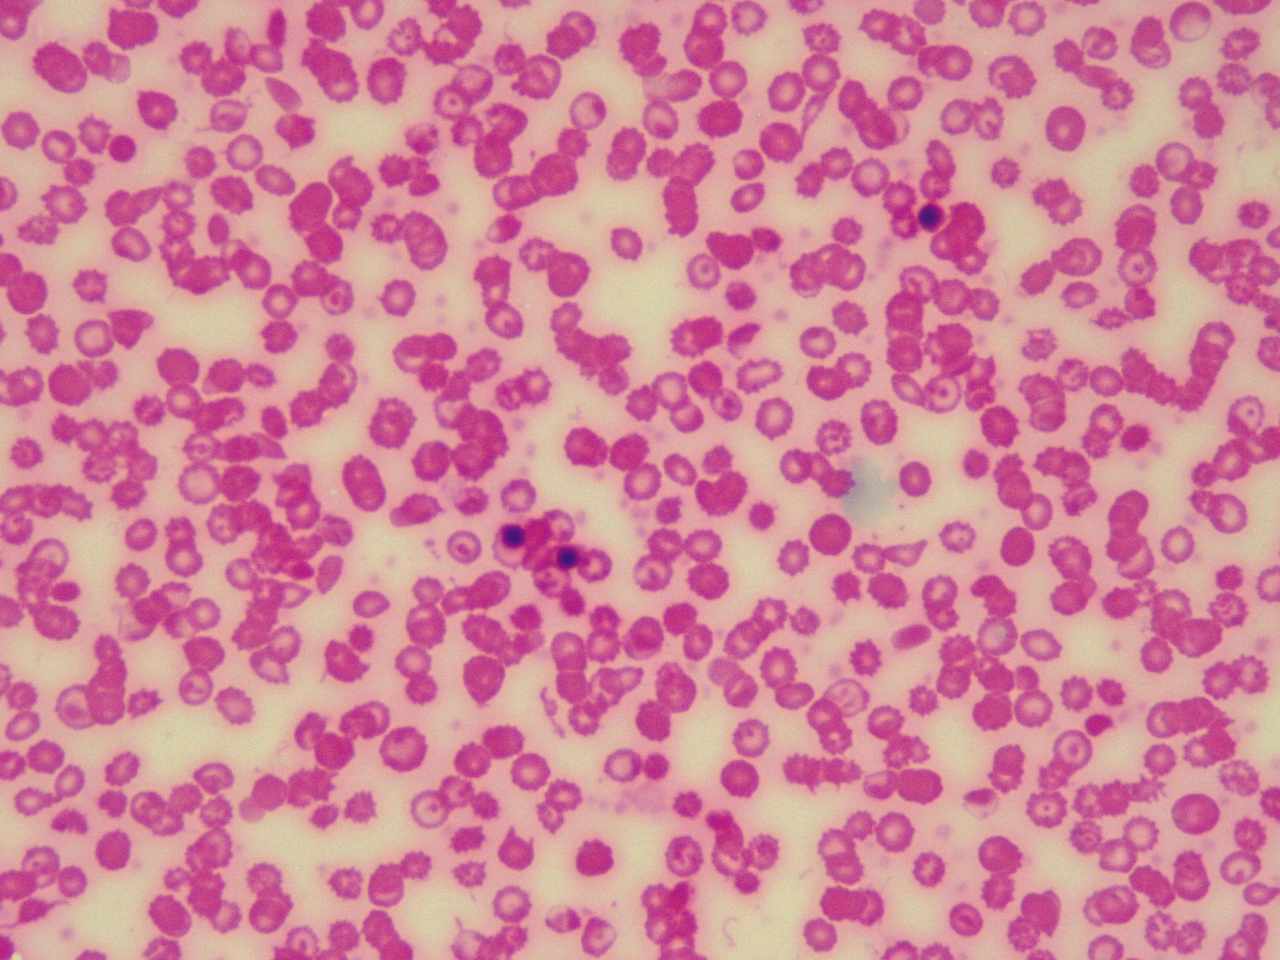

Global Blood Therapeutics Benefits
Food and Drug Administration FDA has accepted. Global Blood Therapeutics NASDAQGBT last released its quarterly earnings results on Tuesday February 23rd.
When you join GBT you join a team that is dedicated to advancing new therapies to improve the lives of underserved patient communities.

Global blood therapeutics benefits. Global Blood Therapeutics has a one year low of 3649 and a one year high of 8369. 1 day agoThe following slide deck was published by Global Blood Therapeutics Inc. 25 2019 GLOBE NEWSWIRE -- Global Blood Therapeutics Inc.
Last year the Food and Drug Administration approved Global Blood Therapeutics NASDAQGBT novel therapy Oxbryta for the treatment of sickle cell disease. They do not constitute an endorsement or an approval by Global Blood Therapeutics. They anticipate the company to incur a.
Our comprehensive compensation and benefits programs protect and improve the lives of our employees and their. Building a thriving team. Global Blood Therapeutics.
05 2019 GLOBE NEWSWIRE -- Global Blood Therapeutics Inc. The Investor Relations website contains information about Global Blood Therapeutics Incs business for stockholders potential investors and financial analysts. The stock that epitomizes the said phenomenon is Global Blood Therapeutics Subsequent to launching Oxbryta GBT shares rallied to a peak of 8376 in early 2020.
In order to extend the benefits of GBT source and our support tools to as many patients as. Explore the many benefits of having a premium branded profile on Glassdoor like increased influence and advanced analytics. Founded in 2011 GBT is delivering on its goal to transform the treatment and care of sickle cell disease SCD a lifelong devastating inherited blood.
Food and Drug Administration FDA has granted accelerated approval for Oxbryta voxelotor tablets for the treatment of sickle cell disease SCD in adults and children 12 years of age and older. 1 Oxbryta an oral therapy. The firm has a 50 day simple moving average of 4192 and a 200 day simple moving average of 4696.
GBT today announced that the US. SOUTH SAN FRANCISCO Calif Nov. GBT today announced that the US.
Global Blood Therapeutics has a beta of 139 meaning that its. Glassdoor is your resource for information about Global Blood Therapeutics benefits and perks. Global Blood Therapeutics GBT came out with a quarterly loss of 121 per share versus the Zacks Consensus Estimate of a loss of 102.
The rewards of a career at GBT are so much more than just compensation and benefits although those are pretty great too. Thereafter the stock has been. Global Blood Therapeutics GBT is a biopharmaceutical company dedicated to the discovery development and delivery of life-changing treatments that provide hope to underserved patient communities.
Benefits information above is provided anonymously by current and former Global Blood Therapeutics employees and may include a summary provided by the employer. The decline came after the company. You are now leaving the Global Blood Therapeutics website You are currently leaving our site.
10 stocks we like better than Global Blood Therapeutics. Global Blood Therapeutics reported net sales of 39 million in the first quarter all of which stemmed from sickle-cell disease drug Oxbryta. External links are being provided as a convenience and for informational purposes only.
Learn about Global Blood Therapeutics including insurance benefits retirement benefits and vacation policy. Shares of Global Blood Therapeutics NASDAQGBT were sinking 8 as of 1114 am. Changes wont be saved until you sign up for an Enhanced Profile subscription.
Global Blood Therapeutics is bordering on breakeven according to the 21 American Biotechs analysts. 19 hours agoGiven Global Blood Therapeutics higher probable upside analysts clearly believe Global Blood Therapeutics is more favorable than Xenetic Biosciences. This result fell well below the average analyst.
SOUTH SAN FRANCISCO Calif Sept. Description Global Blood Therapeutics Inc a biopharmaceutical company engages in the discovery development and delivery of treatments for underserved patient communities.

Http Www Io Nihr Ac Uk Wp Content Uploads 2017 12 10748 Voxelotor For Sickle Cell Disease Pdf

Https Www Sicklecelldisease Org Files Sites 181 2019 12 Gbt Source Patient Brochure Pdf
 Sickle Cell Disease Treatment Market Size Report 2018 2023
Sickle Cell Disease Treatment Market Size Report 2018 2023
 Eric Fink Global Blood Therapeutics
Eric Fink Global Blood Therapeutics

 Pharmacokinetics And Pharmacodynamics Of Voxelotor Gbt440 In Healthy Adults And Patients With Sickle Cell Disease Hutchaleelaha 2019 British Journal Of Clinical Pharmacology Wiley Online Library
Pharmacokinetics And Pharmacodynamics Of Voxelotor Gbt440 In Healthy Adults And Patients With Sickle Cell Disease Hutchaleelaha 2019 British Journal Of Clinical Pharmacology Wiley Online Library
 Blood Market Size Share And Growth Analysis 2020 2027
Blood Market Size Share And Growth Analysis 2020 2027
 Pdf Pharmacokinetics And Pharmacodynamics Of Voxelotor Gbt440 In Healthy Adults And Patients With Sickle Cell Disease
Pdf Pharmacokinetics And Pharmacodynamics Of Voxelotor Gbt440 In Healthy Adults And Patients With Sickle Cell Disease
 Pharmacokinetics And Pharmacodynamics Of Voxelotor Gbt440 In Healthy Adults And Patients With Sickle Cell Disease Hutchaleelaha 2019 British Journal Of Clinical Pharmacology Wiley Online Library
Pharmacokinetics And Pharmacodynamics Of Voxelotor Gbt440 In Healthy Adults And Patients With Sickle Cell Disease Hutchaleelaha 2019 British Journal Of Clinical Pharmacology Wiley Online Library

Post a Comment for "Global Blood Therapeutics Benefits"